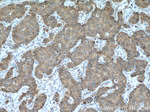
EIF4E Antibody in Immunohistochemistry (Paraffin) (IHC (P))

Search
Proteintech
EIF4E Monoclonal Antibody (3C6B9)
{{$productOrderCtrl.translations['antibody.pdp.commerceCard.promotion.promotions']}}
{{$productOrderCtrl.translations['antibody.pdp.commerceCard.promotion.viewpromo']}}
{{$productOrderCtrl.translations['antibody.pdp.commerceCard.promotion.promocode']}}: {{promo.promoCode}} {{promo.promoTitle}} {{promo.promoDescription}}. {{$productOrderCtrl.translations['antibody.pdp.commerceCard.promotion.learnmore']}}
产品信息
66655-1-IG
种属反应
宿主/亚型
分类
类型
克隆号
抗原
偶联物
形式
浓度
规格
纯化类型
保存液
内含物
保存条件
运输条件
产品详细信息
Immunogen sequence: MATVEPETT PTPNPPTTEE EKTESNQEVA NPEHYIKHPL QNRWALWFFK NDKSKTWQAN LRLISKFDTV EDFWALYNHI QLSSNLMPGC DYSLFKDGIE PMWEDEKNKR GGRWLITLNK QQRRSDLNRF WLETLLCLIG ESFDDYSDDV CGAVVNVRAK GDKIAIWTTE CENREAVTHI GRVYKERLGL PPKIVIGYQS HADTATKSGS TTKNRFVV (1-217 aa encoded by BC012611)
靶标信息
eIF4E is involved in several cellular processes including enhanced translational efficiency, splicing, mRNA stability, and RNA nuclear export. All eukaryotic cellular mRNAs are blocked at their 5-prime ends with the 7-methylguanosine cap structure, m7GpppX (where X is any nucleotide). EIF4E is a eukaryotic translation initiation factor involved in directing ribosomes to the cap structure of mRNAs. It is a 24-kD polypeptide that exists as both a free form and as part of a multiprotein complex termed EIF4F. The EIF4E polypeptide is the rate-limiting component of the eukaryotic translation apparatus and is involved in the mRNA-ribosome binding step of eukaryotic protein synthesis. The other subunits of EIF4F are a 50-kD polypeptide, termed EIF4A, that possesses ATPase and RNA helicase activities, and a 220-kD polypeptide, EIF4G.
仅用于科研。不用于诊断过程。未经明确授权不得转售。
生物信息学
蛋白别名: eIF-4E; eIF-4F 25 kDa subunit; Eukaryotic translation initiation factor 4E; eukaryotic translation initiation factor 4E-like 1; MGC111573; mRNA cap-binding protein; OTTHUMP00000219703; OTTHUMP00000219704; OTTHUMP00000219705; unnamed protein product
基因别名: AUTS19; CBP; EG668879; eIF-4E; EIF4E; Eif4e-ps; EIF4E1; EIF4EL1; EIF4F; If4e
UniProt ID: (Human) P06730, (Mouse) P63073, (Rat) P63074
Entrez Gene ID: (Human) 1977, (Mouse) 13684, (Rat) 117045